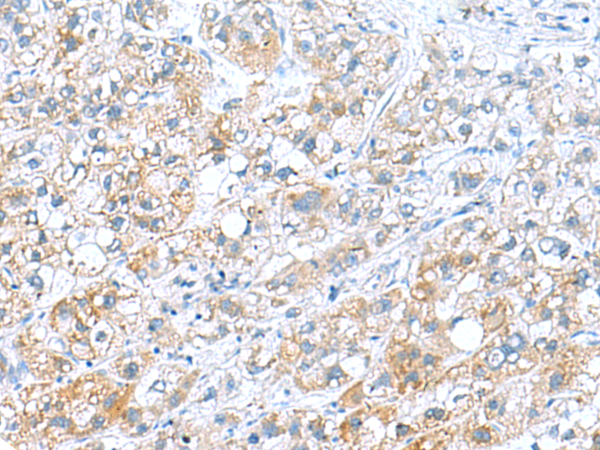

|
Background: |
This gene encodes an axonemal dynein light chain which functions as a component of the outer dynein arms complex. This complex acts as the molecular motor that provides the force to move cilia in an ATP-dependent manner. The encoded protein is expressed in tissues with motile cilia or flagella and may be involved in the movement of sperm flagella. Alternate splicing results in multiple transcript variants.[ |
|
Applications: |
ELISA, IHC |
|
Name of antibody: |
DNAL1 |
|
Immunogen: |
Fusion protein of human DNAL1 |
|
Full name: |
dynein axonemal light chain 1 |
|
Synonyms: |
LC1; CILD16; C14orf168 |
|
SwissProt: |
Q4LDG9 |
|
ELISA Recommended dilution: |
5000-10000 |
|
IHC positive control: |
Human liver cancer |
|
IHC Recommend dilution: |
50-200 |
購物車
購物車 幫助
幫助
 021-54845833/15800441009
021-54845833/15800441009
